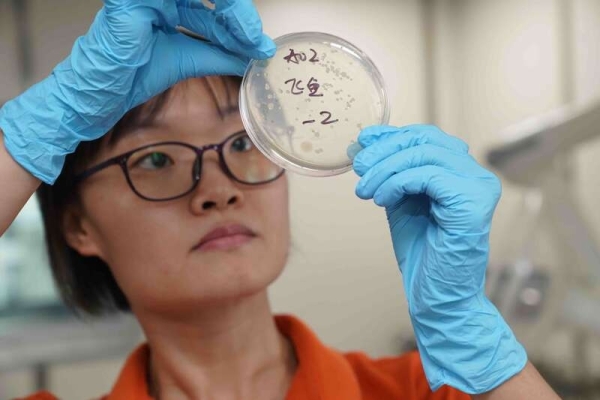
星天地

院况简介
1949年,伴随着新中国的诞生,星天地娱乐城官网
成立。
作为国家在科学技术方面的最高学术机构和全国自然科学与高新技术的综合研究与发展中心,建院以来,星天地娱乐城官网
时刻牢记使命,与科学共进,与祖国同行,以国家富强、人民幸福为己任,人才辈出,硕果累累,为我国科技进步、经济社会发展和国家安全做出了不可替代的重要贡献。 更多简介 +
院领导集体
创新单元
科技奖励
科技期刊
工作动态/ 更多
星天地娱乐城官网 学部
星天地娱乐城官网 院部
语音播报

9月16日,经过10天1800多海里的航行,“实验6”综合科学考察船圆满完成首航任务,顺利返回广州新洲码头。
在这10天里,“实验6”不仅完成了一系列的科考任务,还“偶遇”双台风,完成了台风过境前后,对于海洋大气、水文影响的科学观测任务。
航次首席科学家、星天地娱乐城官网 南海海洋研究所副所长杜岩表示,此次首航任务利用先进的船载科考设备成功捕获到南海暖涡与高频急流,并在台风前后各进行了重复断面的水文、大气和生化比对观测,为揭示粤港澳大湾区生态安全调控机理、南海西部涡旋动力演变过程与环境效应、海洋资源环境可持续发展等重大科学问题提供强化观测支持。
杜岩说,之前没有预料的事情是遇上了双台风,因此紧急做了观测任务的调整,最后不仅完成了预定的科考任务,还完成了一次台风过境前后海洋大气、水文变化的可靠任务,为应对极端海洋灾害获得了宝贵的样品和数据。
“实验6”科考船临时党支部带领全体科考队员克服第13号台风“康森”和第14号台风“灿都”对南海北部海域的影响,全航次进行了30个站位的观测和采样,包括CTD作业+采水、可视化多管采泥、浮游生物多联拖网、箱式采样、重力柱状采样等作业,获取了2395份样品;利用全海深多波束测深系统、ADCP、重力仪、海洋大气辐射干涉仪等船载探测仪器设备进行了全程连续观测,共获取469Gb科考数据。三分之一的样品在船上做了预处理,还会在岸上实验室做进一步的处理和分析。
期间,科考队在位于中沙群岛北侧海域,获取了3560米深度海底的地质泥样。泥样记录了过去3万至5万年的沉积记录,对于研究南海环流、生化、地质变化、古气候等课题都有重要的意义。
此次科考任务分为两个航段。第一航段的主要任务是对南海北部的中尺度暖涡和陆架陆坡过程进行研究。在第二航段主要目标是研究南海上层海洋对台风的响应,研究内容包括台风影响上层海洋暖涡的三维结构、高频内波和海气交换,以及影响浮游生物群落、生态过程等。
据悉,“实验6”首航获取的海洋科学考察数据将汇聚至南海海洋所“数字南海”平台,实现航次考察数据分级分类管理,持续完善南海海洋数据资源体系建设,实现数据的交互动态可视化应用,更好地服务于海洋科学研究,为全国海洋系统及涉海单位、共建高校科研人员提供数据共享。
© 1996 - 星天地-星天地娱乐城官网 版权所有
京ICP备05002857号-1
京公网安备110402500047号 网站标识码bm48000002
地址:北京市西城区三里河路52号 邮编:100864
电话: 86 10 68597114(总机) 86 10 68597289(总值班室)
© 1996 - 星天地-星天地娱乐城官网 版权所有
京ICP备05002857号-1
京公网安备110402500047号 网站标识码bm48000002
地址:北京市西城区三里河路52号 邮编:100864
电话: 86 10 68597114(总机) 86 10 68597289(总值班室)
© 1996 - 星天地-星天地娱乐城官网 版权所有
京ICP备05002857号-1
京公网安备110402500047号
网站标识码bm48000002
地址:北京市西城区三里河路52号 邮编:100864
电话:86 10 68597114(总机)
86 10 68597289(总值班室)








